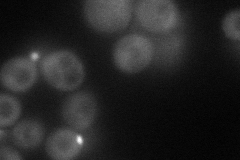
YPL115C
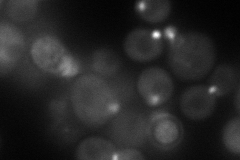
YPL115C
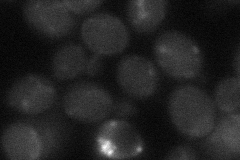
YPL115C

View description
Rho GTPase activating protein (RhoGAP) involved in control of the cytoskeleton organization; targets the essential Rho-GTPase Cdc42p, which controls establishment and maintenance of cell polarity, including bud-site assembly
Localization:
Intensity:
Fold change:
Significance:
-
C’ GFP library in SD

below threshold15.25 -
N' NOP1pr-GFP in SD
bud63.7283 -
N' TEF2pr-mCherry in SD
punctate,bud neck85.8451 -
N' NATIVEpr-GFP in SD

below threshold22.5437 -
N' TEF2pr-VC and Cyto-VN in SD
below threshold27.0187 -
C’ GFP library in SD+DTT

cytosolN/AN/ANo -
C’ GFP library in SD+H2O2

cytosol18.891.23No -
C’ GFP library in Starvation Media

cytosol16.921.1No -
C’ GFP library on the background of Pup2-DaMP

below threshold -
C’ GFP library on the background of CCT mutant

below threshold15.79711.03539No
